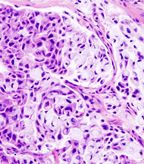

Researchers have developed and tested a nomogram that uses various factors and can predict risk of recurrence in patients with major salivary gland carcinoma.
Researchers have developed and tested a nomogram that helped to quantify the risk of recurrence in patients with major salivary gland carcinoma, according to a study published online in JAMA Otolaryngology-Head & Neck Surgery. The nomogram uses a patient’s age, grade of cancer, presence of vascular invasion, presence of perineural invasion, and presence of nodal metastases to predict risk.
Histopathologic image of mucoepidermoid carcinoma of the major salivary gland; source: KGH, Wikimedia Commons
“We are now able to counsel patients after surgery and explain what the risk of recurrence is for them,” study author Ian Ganly, MD, PhD, of Memorial Sloan-Kettering Cancer Center, told Cancer Network. “This then allows the clinician to decide if any postop treatment is required and also helps the clinician determine how frequent follow-up investigations should be.”
Dr. Ganly and colleagues designed the study with the objective of creating a method to quantify risk of recurrence in individual patients with major salivary gland carcinoma.
“Malignant salivary gland carcinomas are a very heterogeneous group because of not only the mixed histologic types but also their biological behavior,” the researchers wrote. “Although the American Joint Committee on Cancer (AJCC) TNM classification can help predict prognosis, this is applied to an entire population and does not predict the prognosis in an individual patient.”
The researchers conducted a single institution retrospective case series study of 301 patients with previously untreated malignant salivary gland tumors treated between 1985 and 2009.
Patients involved in the study had undergone a median follow-up of 43 months. The 5-year overall mortality was 30% and the disease-specific mortality was 28%. Patients had a recurrence rate of 33%.
Among the patients enrolled in the study, 70 recurrences occurred. The researchers looked at patient, treatment and tumor characteristics to identify predictive factors. Clinical factors identified as predictive of recurrence were sex, comorbidity, facial nerve paralysis, skin involvement, and clinical tumor and node classification. Predictive pathological factors included pathological tumor classification, positive nodes, vascular invasion, perineural invasion, margin status, and grade.
The researchers then identified the five variables that had the highest predictive power for recurrence and used those to develop the nomogram, which had a high concordance index of 0.85.
“Each of the five variables gives a relative risk that can be quantified on a point scale,” the researchers wrote. “Once the total number of points has been tallied for an individual patient, we can use this score to assess how it corresponds with the relative risk of recurrence up to 5 years after surgery, thus giving the patient a relative risk of recurrence after salivary gland surgery.”
The researchers pointed out that the study does have a couple of limitations, including the fact that it was developed from retrospective data and its dependence on the accuracy of those data. However, they added that additional data from validation studies should hopefully add to the robustness of the predictive nomogram in the future.